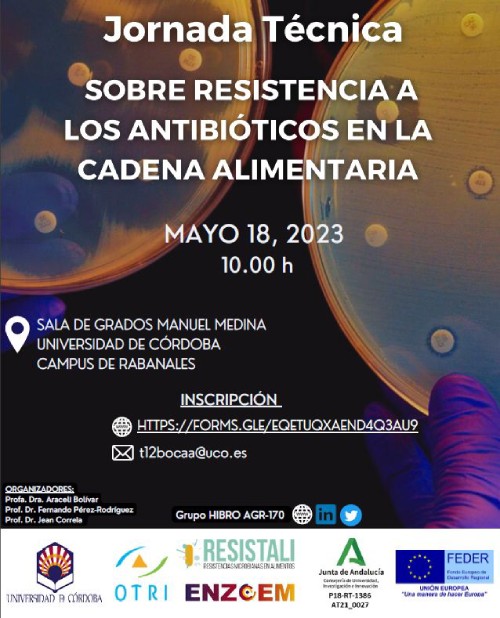

Jornadas y congresos de 2023
Jornada técnica. Sobre resistencia a los antibióticos en la cadena alimentaria.
Fecha: 18 de mayo de 2023
Lugar: Sala de Grados Manuel Medina, Campus de Rabanales, Córdoba, España
Organiza: Grupo HIBRO

I Jornada técnica. Nuevos avances en Cultivos Bio-protectores aplicados a Alimentos
Fecha: 11 de mayo de 2023
Lugar: Sala de Grados Manuel Medina, Campus de Rabanales, Córdoba, España
Organiza: Grupo HIBRO

Jornada técnica: Aplicación de la microbiología predictiva en el Plan Extraordinario contra Listeria monocytogenes de la Junta de Andalucía en alimentos listos para su consumo
Fecha: 26 de enero de 2023
Lugar: Online
Organiza: Grupo HIBRO